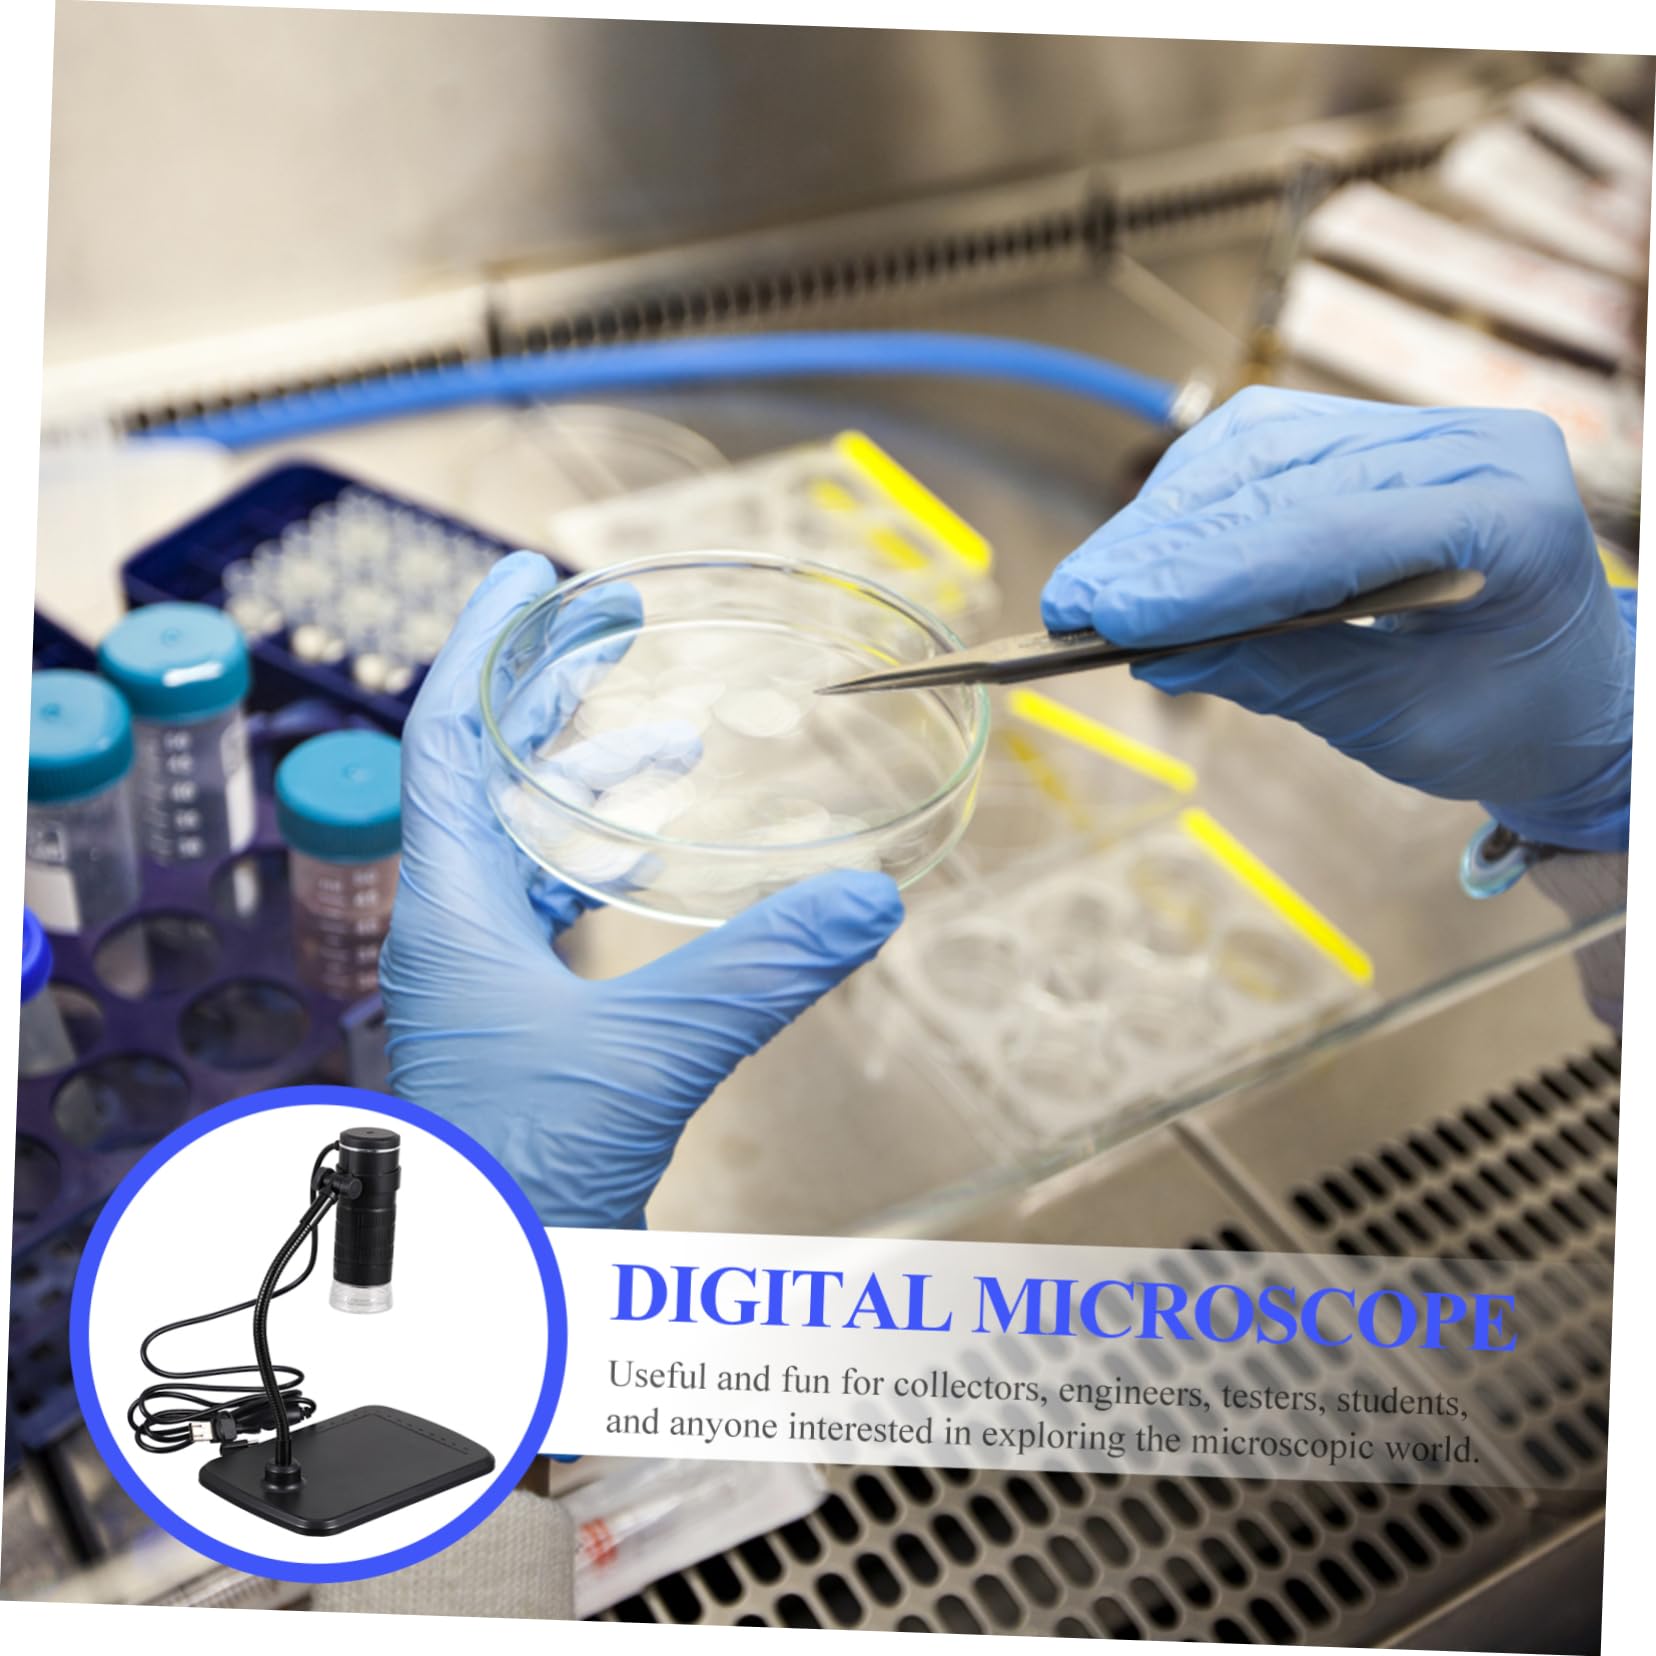
LALAFINA Three-in-one Microscope 1000x Magnification for Cellphone and Jewelry Inspecti

Product Information
Specification
Brand : LALAFINA
BulletPoint1 : Magnification magnifier: high definition picture , 1000x magnification, and 8 built-in adjustable led,USB Digital Microscope
BulletPoint2 : Application range: repair industry, inspection, industrial electronics, laboratory, identification of jade, coins, jewelry, jade ware, porcelain, bronze ware, stamps, antiques and many other fields,cellphone repair microscope,Digital Microscope
BulletPoint3 : Phone microscope:it can be put to any table, desk, bench, worktable or counter,Electronic Microscope
BulletPoint4 : USB magnifier microscope:you could send it to your friends and families as a present and they will be very happy,High-definition Microscope
BulletPoint5 : Wide application: exploration of electronics industry jewelry maintenance interest cultivation, microscope,Microscope
Color : Black
IncludedComponents : Microscope
ItemName : LALAFINA Three-in-one Microscope 1000x Magnification for Cellphone and Jewelry Inspecti
ItemPackageDimensions_Height : 1.97 inches
ItemPackageDimensions_Length : 7.09 inches
ItemPackageDimensions_Width : 4.92 inches
ItemPackageQuantity : 1
ItemTypeKeyword : science-lab-handheld-digital-microscopes
Manufacturer : LALAFINA
Material : Plastic
ModelName : USB Microscopes
ModelNumber : AP2520YM48G1G1NGJZIYPRU
PartNumber : AP2520YM48G1G1NGJZIYPRU
ProductDescription : Package List
1 x Microscope
Features
- Resolution: High-definition Microscope.
- Material: Plastic Electronic Microscope.
- Magnification:1000X USB Microscope.
- Size: 22.00X17.00X12.00cm/8.65X6.68X4.72 inch Three-in-one Microscope.
- Color: Black Cellphone Repair Microscope.
- More than a microscope. It can take pictures and record videos like a camera USB Magnifier Microscope.
- high definition picture , 1000X magnification, and 8 built-in adjustable LED Cellphone Microscope.
- Lightweight and small size allows you to observe plants, minerals, on your trips USB Digital Microscope.
- Fine workmanship and creative appearance ensure its popularity and practicality Digital Microscope.
- Useful and fun for collectors, engineers, testers, students, and anyone interested in exploring the microscopic Microscope.
Goods Description
Magnification Magnifier Featuring 1000X magnification can satisfy of your needs, this digital microscope can be easily worked and focused on by using the barrel focus wheel.Microscope Camera This digital microscope is made of material, durable and practical
ProductSiteLaunchDate : 2025-04-02T13:48:18.148Z
Size : 22X17X12CM
Style : Modern
SupplierDeclaredDgHzRegulation : not_applicable
UnspscCode : 41111700